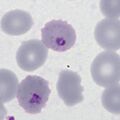

Unused files
The following files exist but are not embedded in any page. Please note that other websites may link to a file with a direct URL, and so may still be listed here despite being in active use.
Showing below up to 50 results in range #1 to #50.
-
Species.jpg 472 × 472; 63 KB
-
Lifecycle.jpg 709 × 840; 211 KB
-
RDT multi no band1.jpg 129 × 354; 38 KB
-
RDT multi no band2.jpg 129 × 354; 39 KB
-
RDT multi no band3.jpg 129 × 354; 39 KB
-
RDT multi no band4.jpg 129 × 354; 39 KB
-
RDT multi pos1.jpg 129 × 354; 39 KB
-
RDT multi pos2.jpg 129 × 354; 39 KB
-
Blood stages schizonts only.jpg 472 × 472; 77 KB
-
Ageing.jpg 472 × 472; 62 KB
-
Mosquito.jpg 472 × 472; 68 KB
-
PFG2.jpg 472 × 472; 41 KB
-
James1.jpg 472 × 472; 48 KB
-
Mmaurer1.jpg 472 × 472; 35 KB
-
Mmaurer2.jpg 472 × 472; 58 KB
-
Schuffner1.jpg 472 × 472; 43 KB
-
PFG1mag.jpg 472 × 472; 40 KB
-
PFETinfo.jpg 472 × 472; 201 KB
-
PFET3mag.jpg 472 × 472; 79 KB
-
PFLTinfo.jpg 472 × 472; 44 KB
-
PFSinfo.jpg 472 × 472; 49 KB
-
PFGinfo.jpg 472 × 472; 53 KB
-
PVETinfo.jpg 472 × 472; 69 KB
-
PVSinfo.jpg 472 × 472; 71 KB
-
PVLTinfo.jpg 472 × 472; 70 KB
-
PVGinfo.jpg 472 × 472; 93 KB
-
POETinfo.jpg 472 × 472; 60 KB
-
POLTinfo.jpg 472 × 472; 70 KB
-
POSinfo.jpg 472 × 472; 72 KB
-
POGinfo.jpg 472 × 472; 69 KB
-
Species2.jpg 472 × 472; 69 KB
-
4 PV schizont.jpg 472 × 472; 49 KB
-
4 PV schizont or LT.jpg 472 × 472; 53 KB
-
4 PV schizont or LT anno.jpg 472 × 472; 55 KB
-
4 PV schizont-anno.jpg 472 × 472; 47 KB
-
4 schiz PV anno.jpg 472 × 472; 47 KB
-
4 LT PO a.jpg 472 × 472; 54 KB
-
4 LT PO a anno.jpg 472 × 472; 56 KB
-
4 PV ET anno.jpg 472 × 472; 52 KB
-
4 LT PO dots anno.jpg 472 × 472; 52 KB
-
4 LT PO dotsb.jpg 472 × 472; 54 KB
-
4 LT PO dotsb anno.jpg 472 × 472; 54 KB
-
4 PO schizorLT anno.jpg 472 × 472; 50 KB
-
4 PF gametocyte a.jpg 472 × 472; 57 KB
-
4 PF gametocyte anno.jpg 472 × 472; 59 KB
-
4 PF gametocyte b anno.jpg 472 × 472; 62 KB
-
5 Pigment neut anno.jpg 472 × 472; 62 KB
-
5 PM gametocyte anno.jpg 472 × 472; 52 KB
-
5 PO gametocyte anno.jpg 472 × 472; 59 KB
-
4 ET PO anno.jpg 472 × 472; 89 KB